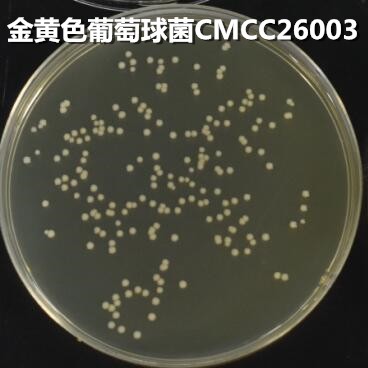
新闻图片2

青岛高科技工业园海博生物技术有限公司
11 年
手机商铺
商家活跃:
产品热度:
- NaN
- 0.20000000000000018
- 0.20000000000000018
- 2.2
- 2.2
酪胨琼脂培养基(2020中国兽药典) HB5205-1 250g
¥120
推荐产品
公司新闻/正文
酪胨琼脂培养基的使用原理及方法(青岛海博生物原创)
1140 人阅读发布时间:2022-11-21 14:25
一、实验用途及原理:
用途:用于药品,生物制品无菌试验。
原理:胰蛋白胨、大豆蛋白胨提供氮源、维生素和生长因子;葡萄糖提供碳源,氯化钠、磷酸氢二钾维持均衡的渗透压;琼脂是培养基的凝固剂。
二、培养基配方(g/L):
| 胰蛋白胨 |
17 |
| 大豆蛋白胨 |
3 |
| 葡萄糖 |
2.5 |
| 氯化钠 |
5 |
| 磷酸氢二钾 |
2.5 |
| 琼脂 |
15 |
| pH 7.2-7.5 25℃ |
|
三、实验方法:
称取本品45.0g,溶解于1000mL 蒸馏水中分装,121℃高压灭菌15分钟,冷至45-50℃时,倾入无菌平皿。
使用前,把制备好的平板放置室温10-20分钟。
1、制备质控菌液
2、将质控菌液涂布平板。
3、36℃倒置需氧培养18-24小时,记录实验结果。
四、结果判定:
| 质控菌株 |
菌株编号 |
接种量(CFU) |
生长情况 |
其他特征 |
| 白色念珠菌 |
CMCC 98001 |
50-100 |
+++ |
白色、圆形菌落 |
| jin黄色葡萄球菌 |
CMCC 26003 |
50-100 |
+++ |
产黄色素、圆形菌落 |
| 大肠埃希氏菌 |
CMCC 44102 |
50-100 |
+++ |
无色、圆形菌落 |
 |
|
 |
图1 酪胨琼脂培养基微生物质控结果
酪胨琼脂培养基(2020中国兽药典)-产品详情
http://www.hopebiol.com/asphtml/product3536.htm
注:本文属海博生物原创,未经允许不得转载。






